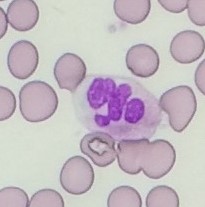
図15-1

読者のみなさま
カラー写真提供サイトにご訪問くださりありがとうございます。
各画像はタップ、あるいはクリックすることで拡大することができます。
カラー写真提供サイトにご訪問くださりありがとうございます。
各画像はタップ、あるいはクリックすることで拡大することができます。

 図8-2(82頁)
図8-2(82頁)
 図9-1-1
図9-1-1
 図9-1-2
図9-1-2
 図9-1-3
図9-1-3
 図9-1-4
図9-1-4
 図14-1-1
図14-1-1
 図14-1-2
図14-1-2
 図14-5
図14-5
 図14-6
図14-6
| 定価 | 3,520円(本体 3,200円+税10%) |
| 著 | 山中克郎 諏訪中央病院 総合診療科 |
| 判型・頁 | A5判・148頁 |
| ISBN978-4-7653-2046-7 C3047 | 2025年3月刊行 |